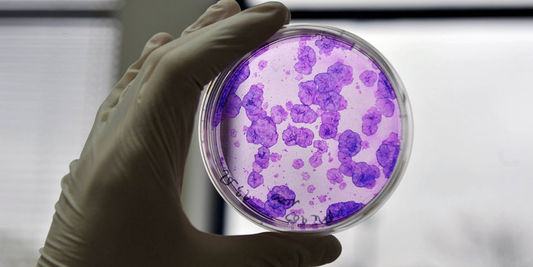

Come radicali dell’Associazione Luca Coscioni abbiamo già iniziato a raccogliere adesioni di Parlamentari che si impegnino verso l’obiettivo di abolire anche in Italia il divieto oscurantista alla ricerca sugli embrioni. Così come in Francia il voto a favore è stato trasversale e ha coinvolto anche esponenti dell’opposizione, mi auguro che anche in Italia i Parlamentari scelgano di agire secondo coscienza, ascoltando di meno gli ordini di scuderia di partito e ascoltando di più gli scienziati, i malati e l’opinione pubblica.
La Francia ha legalizzato la ricerca sugli embrioni. Chiediamo all’Italia di fare altrettanto

L’Associazione Luca Coscioni è una associazione no profit di promozione sociale. Tra le sue priorità vi sono l’affermazione delle libertà civili e i diritti umani, in particolare quello alla scienza, l’assistenza personale autogestita, l’abbattimento della barriere architettoniche, le scelte di fine vita, la legalizzazione dell’eutanasia, l’accesso ai cannabinoidi medici e il monitoraggio mondiale di leggi e politiche in materia di scienza e auto-determinazione.